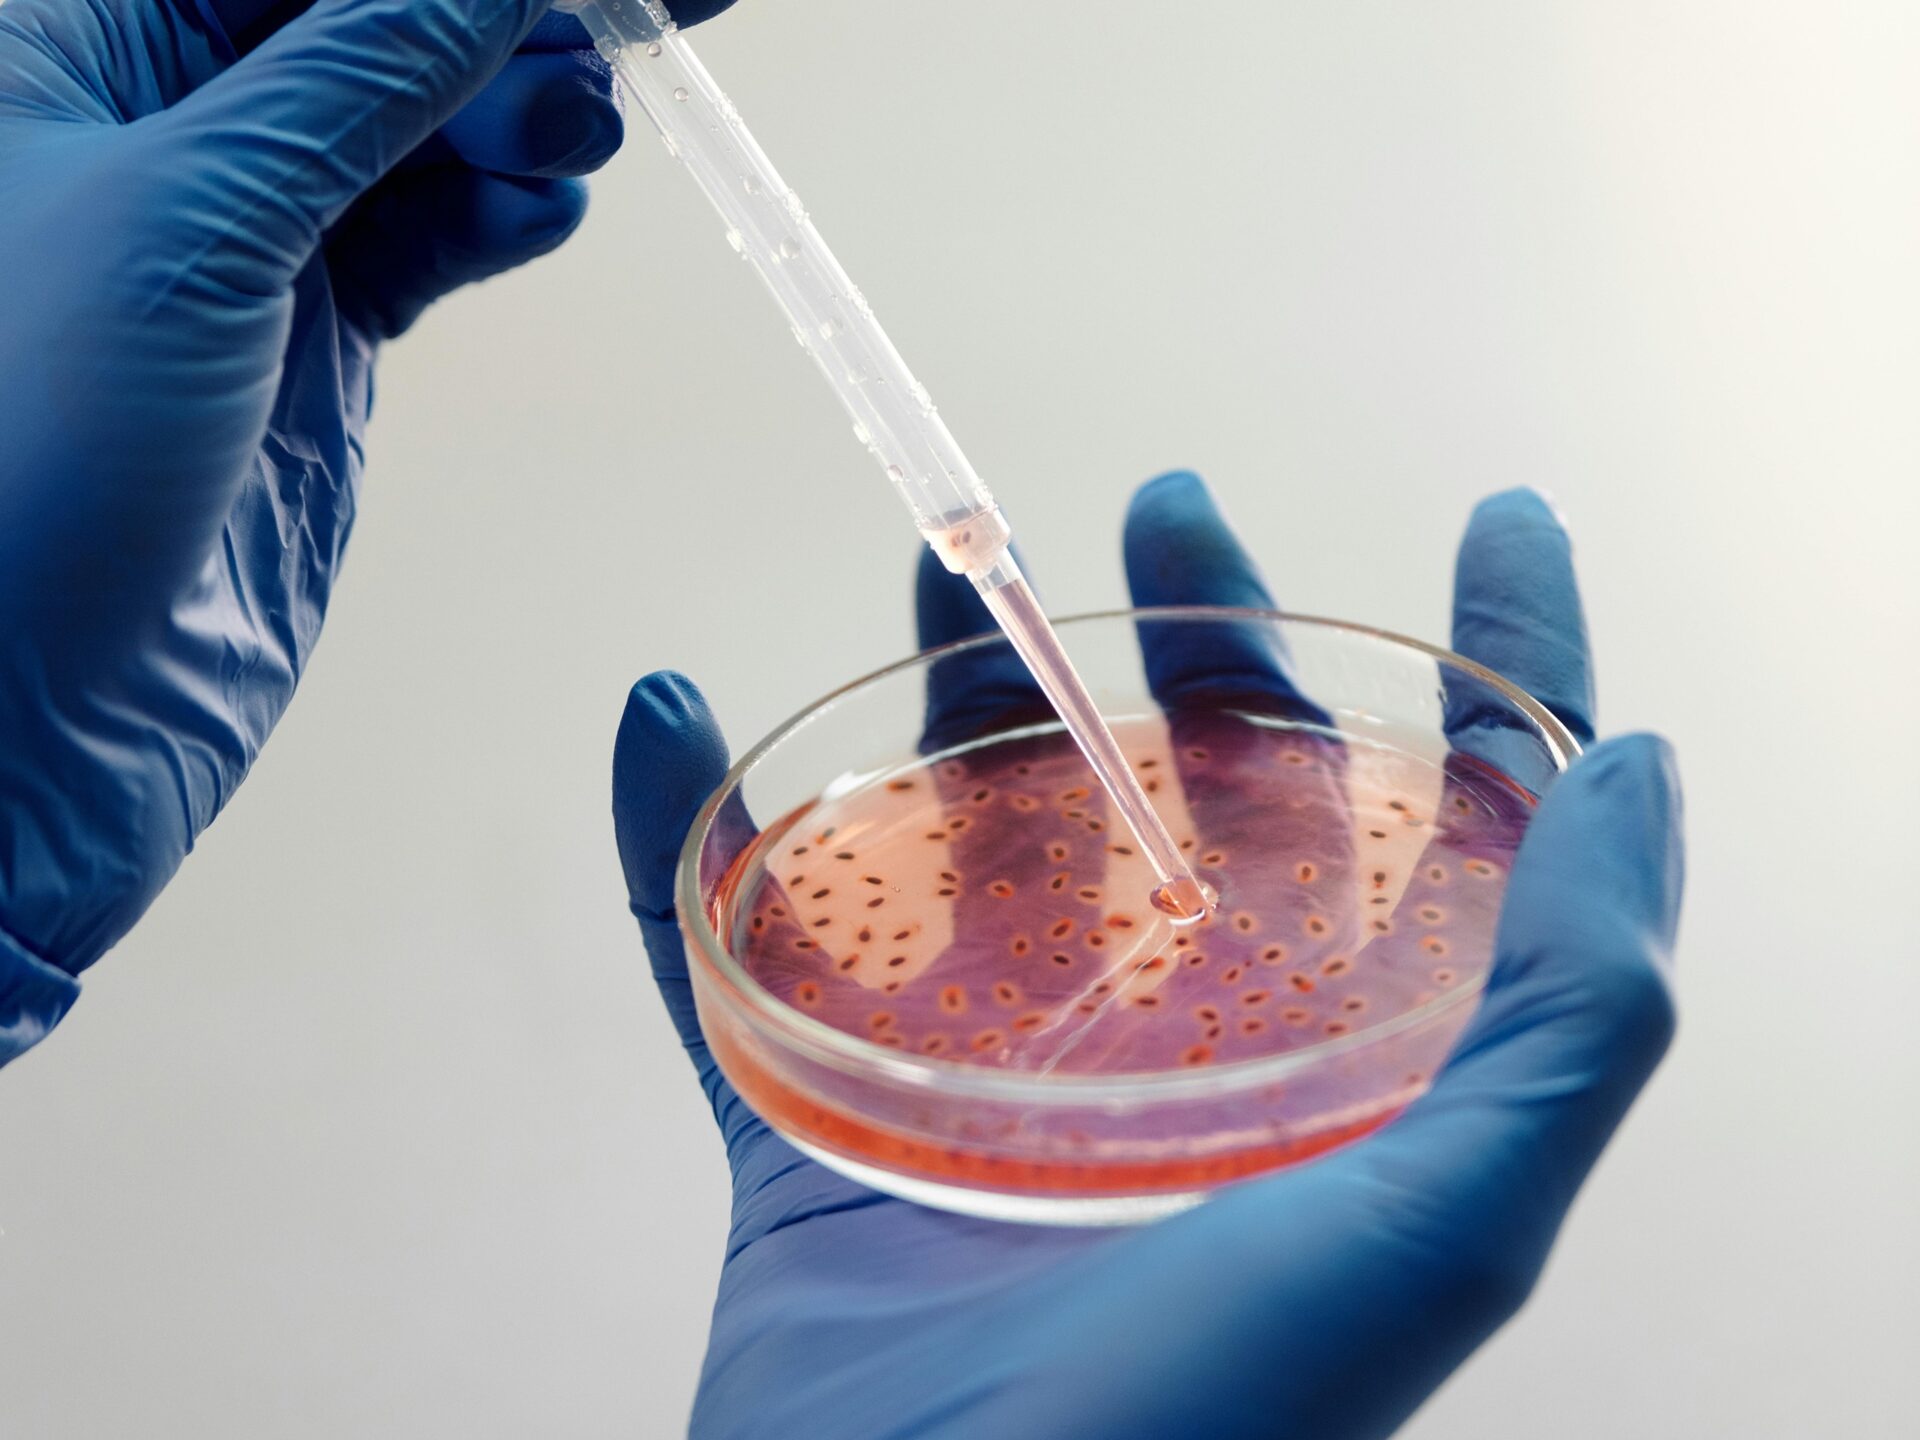

Universal Specimen Transport Medium for Microbes: Sample Preservation
Introduction:
Microbiological research plays a pivotal role in understanding the diverse microbial world and its impact on human health, the environment, various industries, and society as a whole. Collecting and transporting microbial samples accurately and efficiently is crucial for preserving their viability and genetic integrity. In recent years, the development of a universal specimen transport medium (USTM) has revolutionized the field of microbiology, offering a reliable solution for the preservation and transportation of microbes. In this blog, we will explore the significance of USTM, working principles, advantages, and applications in diverse areas of microbiology. So let’s dive right in!
Understanding Universal Specimen Transport Medium (USTM)
Universal Specimen Transport Medium is a specialized solution that enables the safe collection, preservation, and transportation of various microbes, including bacteria, viruses, and fungi. It provides an ideal environment to maintain the viability and genetic stability of microorganisms during transit. This ensures accurate laboratory analysis and results. It is called universal as it can preserve and transport all sorts of microbes like bacteria, fungi, and viruses, including aerobic and anaerobic species.
Working Principles of USTM
USTM is typically composed of several vital components that work synergistically to preserve microbial samples. These components include-
- Buffered Saline Solution: USTM contains a buffered saline solution to maintain a pH range that is favorable for microbes and their survival and growth.
- Protein Stabilizers: Protein stabilizers, such as bovine serum albumin (BSA) may be used to help protect microbial proteins from denaturation during transportation for the microbiology field.
- Antibiotics and Antifungals: USTM may incorporate broad-spectrum antibiotics and antifungals to inhibit the growth of contaminating bacteria and fungi while preserving the target microorganisms.
- Cryoprotectants: Cryoprotectants, like glycerol or dimethyl sulfoxide (DMSO), may sometimes be added to USTM to protect microbial cells from damage caused by freezing or thawing.
The working principles of universal transport medium involve creating an environment that supports microbes and microbial survival. Also, it minimizes any potential changes in the genetic material or physiology of the microorganisms during transit. The solution ensures the specimens’ stability and integrity until they reach the laboratory. Then it can be used for further analysis in the field of microbiology, medicine, or any other.
Advantages of Universal Specimen Transport Medium
A universal specimen transport medium offers key advantages over traditional transport methods, making it an indispensable tool for microbiologists and microbiology. Let us look at some of these advantages:
- Viability Preservation: A universal specimen transport medium provides an optimal environment for microbial viability, ensuring that microbes arrive at the laboratory in a viable state. This allows for accurate and reliable analysis and results.
- Genetic Stability: The composition of USTM helps preserve the genetic material of microorganisms, preventing any degradation or alteration that could compromise subsequent genetic analysis.
- Broad Applicability: The universal specimen transport medium is suitable for a wide range of microorganisms, including bacteria, viruses, fungi, and many more, making it a versatile solution for different research areas and diagnostic applications.
- Extended Shelf Life: This kind of universal specimen transport medium is used to enhance the shelf life of microbial specimens, reduce the need for immediate testing, and enable longer transportation times for microbes.
- Simplicity and Convenience: USTM is easy to use, requiring minimal training and expertise. It simplifies the collection and transportation process, facilitating the work of researchers and healthcare professionals together.
Applications of Universal Specimen Transport Medium
USTM finds its applications across various fields of microbiology, contributing to advancements in research, diagnostics, and public health:
- Infectious Disease Diagnostics: Such a universal specimen transport medium used for the collection and transport of clinical specimens for accurate diagnosis of infectious diseases, such as respiratory infections, sepsis, sexually transmitted infections, and gastrointestinal disorders helps in more ways than one.
- Environmental Microbiology: USTM enables the collection and transportation of environmental samples, allowing researchers to study the microbial composition of soil, water, and air. This aids in understanding ecosystem dynamics, pollution monitoring, and bioremediation efforts in terms of the microbes present in them.
- Food and Beverage Industry: A universal specimen transport medium facilitates the safe transportation of food and beverage samples, ensuring the detection of microbial contaminants and supporting quality control measures for microbiology studies.
- Research and Surveillance: USTM is essential for research studies and surveillance programs involving microbial monitoring, tracking emerging pathogens, and investigating disease outbreaks.
- Veterinary Medicine: USTM assists in collecting and transporting animal specimens for veterinary diagnostics. This mainly aids in the detection and control of infectious diseases in animals due to microbes.
The Solution
Now, if you are wondering where to find such a universal medium, we got you covered!
Ruhvenile® Biomedical offers a revolutionary universal specimen transport medium called BiomLife®. It offers applications in diverse areas of clinical and scientific research. One can store both aerobic and anaerobic microbes in it. It could be bacteria, fungi, or viruses and they can even be stored together without any damage to each other. This product maintains the viability and stability of all kinds of microbes (bacteria, viruses, fungi) without any proliferation. Moreover, it also ensures the integrity of nucleic acids (DNA/ RNA). Without the requirement of any cold chain facility, it can be stored at room temperature for up to 48 hours. This could extend up to more than 720 days when stored at -80°C. Our product has a wide range of applications. This includes the preservation & transportation of microbes without any proliferation. This is highly suitable for advanced OMICS such as metagenomics, functional genomics, proteomics, and many more.
Currently, we are supplying our product to many clients. This includes AIIMS-New Delhi, MAX Healthcare, John Hopkins University, the National Institute of Immunology (NII), and many other renowned institutions. You can check out the product here: https://www.ruhvenile.com/productsandtechnology/biomlife/.
Conclusion:
The development of USTM has significantly enhanced the field of microbiology. This has revolutionized the way microbial samples are collected and transported. USTM offers numerous advantages, including viability preservation, genetic stability, broad applicability, extended shelf life, and simplicity. Its applications include infectious disease diagnostics, environmental microbiology, the food and beverage industry, research and surveillance, and veterinary medicine. As USTM continues to evolve, it will undoubtedly contribute to further advancements in microbiological research. This will help improve our understanding of microbes and their impact on various aspects of life.
Are you interested in buying a revolutionary transport medium? Have any questions about the product? Head on to our website and contact us to arrange a meeting with our scientists to clarify your doubts. Check out the product here: https://www.ruhvenile.com/productsandtechnology/biomlife/




